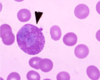
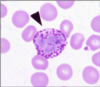
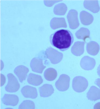
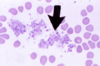

Immuno Histology Flashcards
(36 cards)
Granulocytes (3)
Neutrophils Eosinophils Basophils
Agranulocytes (2)
Monocytes Lymphocytes
Size ranking of blood elements
Monocytes > Eosinophils/Neutrophils > Lymphocytes/Basophils > Erythrocytes > Platelets
Leukocyte % ranking
Neutrophils > Lymphocytes > Monocytes > Eosiniphils > Basophils

Neutrophil
Eosinophil
Basophil
Lymphocyte

Monocyte
Platelets

Proerythroblast

Basophilic erythroblast

Polychomatophilic erythroblast

Orthochomatophilic erythroblast

Reticulocyte

Promyelocyte

Neutrophilic myelocyte

Neutrophilic metamyelocyte

Neutrophilic stab (band) cell
Encapsulated lymphoid tissues (4)
- Thymus
- Tonsils
- Lymph nodes
- Spleen
Diffuse Lymphoid Tissue
MALT (BALT, GALT)
T-cell movement in Thymus
Cortex –> Medulla as they mature
Blood Thymus Barrier
- Capillary endothelium and basal lamina
- Perivascular connective tissue (e.g., macrophages)
- Thymic epithelial “reticular” cells and basal lamina


Thymus (Capsule, Cortex, Medulla)
T-Cells, No B-cells











